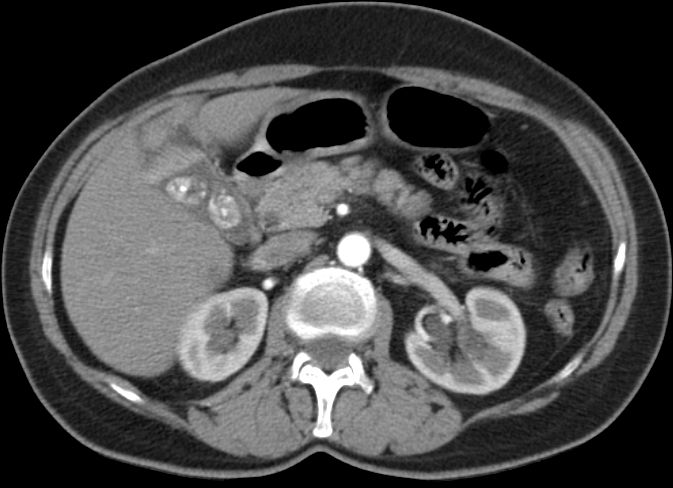
CT

Gallenblasen - Karzinom

Allgemeines
IGBC
| Gruppe | 2. OP | OS |
| A | <4 W | 17,4 M |
| B | 4-8 W | 40,4 M |
| C | > 8 W | 22,4 M |
207 Patienten aus 10 amerikanischen Zentren
Metastasierung

Morphologie
Therapie
Operation
adjuvante Radiatio - Chemotherapie
adjuvante Chemotherapie
Teil von
Quellen
Surgical management of gallbladder cancer.
Surg Oncol Clin N Am 18(2009):307-324
2.) de Aretxabala X, et al:
Chemoradiotherapy in gallbladder cancer.
J Surg Oncol 93(2006):699-704
3.) Kresl JJ, Schild SE, Henning GT, et al:
Adjuvant external beam radiation therapy with concurrent chemotherapy in the management of gallbladder carcinoma.
IJROBP 52(2002):167-175
4.) Czito BG, Hurwitz HI, Clough RW, et al:
Adjuvant external-beam radiotherapy with concurrent chemotherapy after resection of primary gallbladder carcinoma: A 23-year experience.
IJRaOBP 62(2005):1030-1034
5.) Baeza MR, Reyes JM, del Castillo C:
Postoperative adjuvant radiochemotherapy in the treatment of gallbladder cancer.
Presented at the 47th Annual Meeting of the American Society of Therapeutic Radiation Oncology, Denver, CO, October 16-20, 2005
6.) Gold DG, Miller RC, Haddock MG, et al:
Adjuvant therapy for gallbladder carcinoma: The Mayo Clinic experience.
IJROBP 75(2009):150-155
7.) Cho SY, Kim SH, Park SJ, et al:
Adjuvant chemoradiation therapy in gallbladder cancer.
J Surg Oncol 102(2010):87-93
8.) Ethun CG, et al.:
Association of optimal time interval to re-resection for incidental gallbladder cancer with overall survival.
JAMA Surg 2016;
DOI: 10.1001/jamasurg. 2016.3642.
9.) Agopian VG, et al.:
The timing of reoperation for incidental gallbladder cancer: sooner or later?
JAMA Surg 2016;
DOI: 10.1001/jamasurg.2016.3643